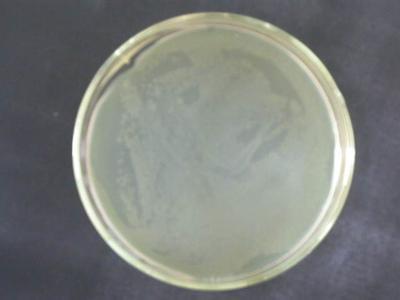
萘啶酮酸(9mg)

产品分类
- 实验抗体 (5713)
- ATCC细胞 (1038)
- elisa定量检测试剂盒 (2839)
- RNA/DNA提取 (1051)
- 标准品 (599)
- Sigma试剂 (2801)
- 培养基 (1324)
- 酶联免疫分析试剂盒 (3087)
- ELISA检测试剂盒 (862)
- 生物抗体 (955)
- PCR试剂盒 (1514)
- DRG试剂盒 (738)
- 原代细胞 (271)
- 标准物质 (1186)
- 生化检测试剂盒 (820)
- 生化试剂 (1001)
- 生化试剂类 (772)
- 细胞生物学 (2236)
- 抗体 (20040)
- 进口品牌 (219)
- 生物碱 (485)
- 黄酮 (523)
- 查尔酮 (50)
- 氧杂蒽酮 (26)
- 木脂素 (213)
- 香豆素 (120)
- 苯丙素 (47)
- 药物杂质及中间体 (805)
- 其它天然产物 (134)
- 蒽醌 (24)
- 其它醌类 (39)
- 甾体 (133)
- 二萜 (386)
- 其它萜类 (49)
- 环烯醚萜 (89)
- 倍半萜 (351)
- 其它酚类 (490)
- 三萜 (425)
- 中药对照品系列 (1311)
- 精细化学 (545)
- 进口试剂盒 (2076)
- 细胞生物学 (721)
- 鉴定试剂盒 (922)
- 细胞库 (631)
- 培养基/实验耗材 (1159)
- 感受态菌株 (2015)
- 蛋白与免疫 (5839)
- 耗材和仪器 (1)
- 分子生物学 (511)
- 抗体 (3338)
- 细胞系 (554)
- LAMP试剂盒 (1504)
- 荧光定量PCR试剂盒 (1122)
- 标准溶液 (1343)
- ELISA Kit (2829)
- ELISA检测试剂盒 (3492)
- 进口PCR试剂 (4901)
- 进口ELISA试剂盒 (4994)
- 蛋白 (2506)
- 其他分类 (14)